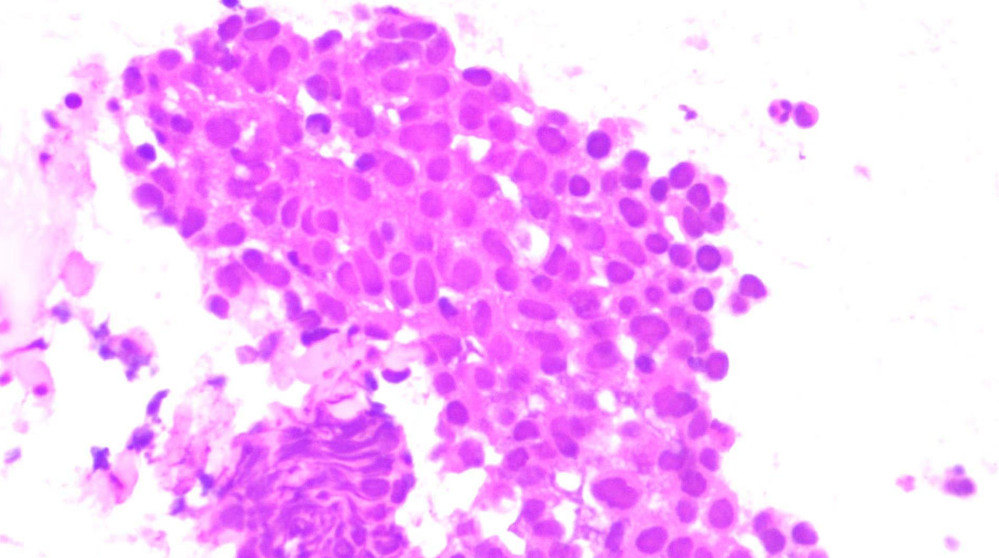

时间:2026-04-09 来源:江门市中心医院 编辑:陈美玲 林翠蓉

在肿瘤诊疗过程中,精准病理诊断是制定科学治疗方案的基石。对于位置深在、隐匿复杂的病灶,如何在确保安全的前提下获得准确组织标本,往往是临床面临的重大挑战。
一例鼻咽癌患者病灶转移探寻诊治,充分体现了江门市中心医院耳鼻咽喉头颈外科联合呼吸与危重症医学科、麻醉科,组建多学科团队(MDT)开展协作诊疗,创新性应用超声支气管镜引导下针吸活检术的重大临床价值。该案例成功确诊了鼻咽癌患者放疗后出现的鼻咽深部转移病灶。标志着我院在鼻咽-颅底肿瘤微创精准诊断领域取得突破性进展。

疑难病例
深部病灶致常规活检受限
患者为74岁男性,既往接受鼻咽癌根治性放射治疗。本次随访复查MRI提示:右侧椎前间隙出现软组织结节,并侵犯头长肌;PET-CT高度怀疑肿瘤转移。


为进一步明确病理性质,门诊行电子鼻咽镜检查并尝试活检,但因病灶位置深在、解剖结构复杂、常规路径难以抵达核心区域,未能取得阳性结果。
在缺乏病理依据的情况下,患者后续治疗方案无法精准制定,诊断一度陷入僵局。

多学科协作
创新思路,打开诊断新通道
面对这一棘手问题,我院迅速启动多学科会诊机制。耳鼻咽喉头颈外科与呼吸与危重症医学科专家深入讨论后,提出突破性方案——借助超声支气管镜(EBUS)经鼻腔,对鼻咽后壁深部病灶实施实时影像引导下针吸活检。
这一方案大胆突破传统操作路径,将原本广泛应用于肺部及纵隔疾病诊断的技术,创新性延伸至鼻咽深部-颅底病灶取材领域,为解决诊断难题提供了全新思路。

技术突破
精准、安全、微创
术中依托超声支气管镜实时成像系统,动态显示病灶位置及周围血管结构,实现穿刺路径可视化。
在精准导航下,穿刺针准确进入MRI所示可疑结节区域,同时有效避开重要血管和神经结构,大幅提升操作安全性与取材成功率。


耳鼻咽喉科团队精准把握鼻咽——颅底的复杂解剖结构,呼吸内镜介入专家熟练操控超声支气管镜完成精准穿刺,两学科优势互补,突破单一专科技术边界,充分体现了我院多学科协作模式在疑难复杂病例中的强大实力。

明确诊断
为精准治疗按下“启动键”
在多学科团队密切配合下,手术顺利完成并成功获取有效组织标本。最终病理结果明确为鼻咽癌转移灶阳性。

这一关键诊断结果,为患者后续个体化放疗或系统治疗方案的制定提供了决定性依据,使治疗路径更加科学、精准,避免延误和盲目治疗风险。

临床意义
拓展鼻咽
颅底肿瘤微创诊断新边界
本例手术的成功开展,标志着我院在鼻咽——颅底隐匿性肿瘤微创诊断方面实现新突破,具有重要示范意义:
1.拓展超声支气管镜在鼻咽-颅底肿瘤中的创新应用
2.为鼻咽深部病灶提供新的安全取材路径
3.降低开放手术活检风险
4.提升疑难病例诊断效率
这一成功实践,生动诠释了技术创新与多学科协作在精准医疗中的核心价值。

以创新驱动发展
以精准守护生命
精准诊断,是精准治疗的第一步。此次创新性技术应用,是我院持续推进内镜微创技术发展、深化多学科协作机制的重要成果,也体现了医疗团队勇于探索、敢于突破的专业精神。
未来,我院将继续秉持“以患者为中心”的服务理念,不断探索前沿技术,优化诊疗流程,提升疑难复杂疾病诊治能力,为更多患者带来更加精准、安全、高效的医疗服务,为生命护航。
撰稿:陈美玲 林翠蓉
二审:呼吸与危重症医学科 仝金斋 耳鼻咽喉头颈外科 常明章 统战宣传科 谭淑欣
三审:医务部 张春来 统战宣传科 廖欣
编辑:杨嘉蔚 徐蓓蓓(江门日报)